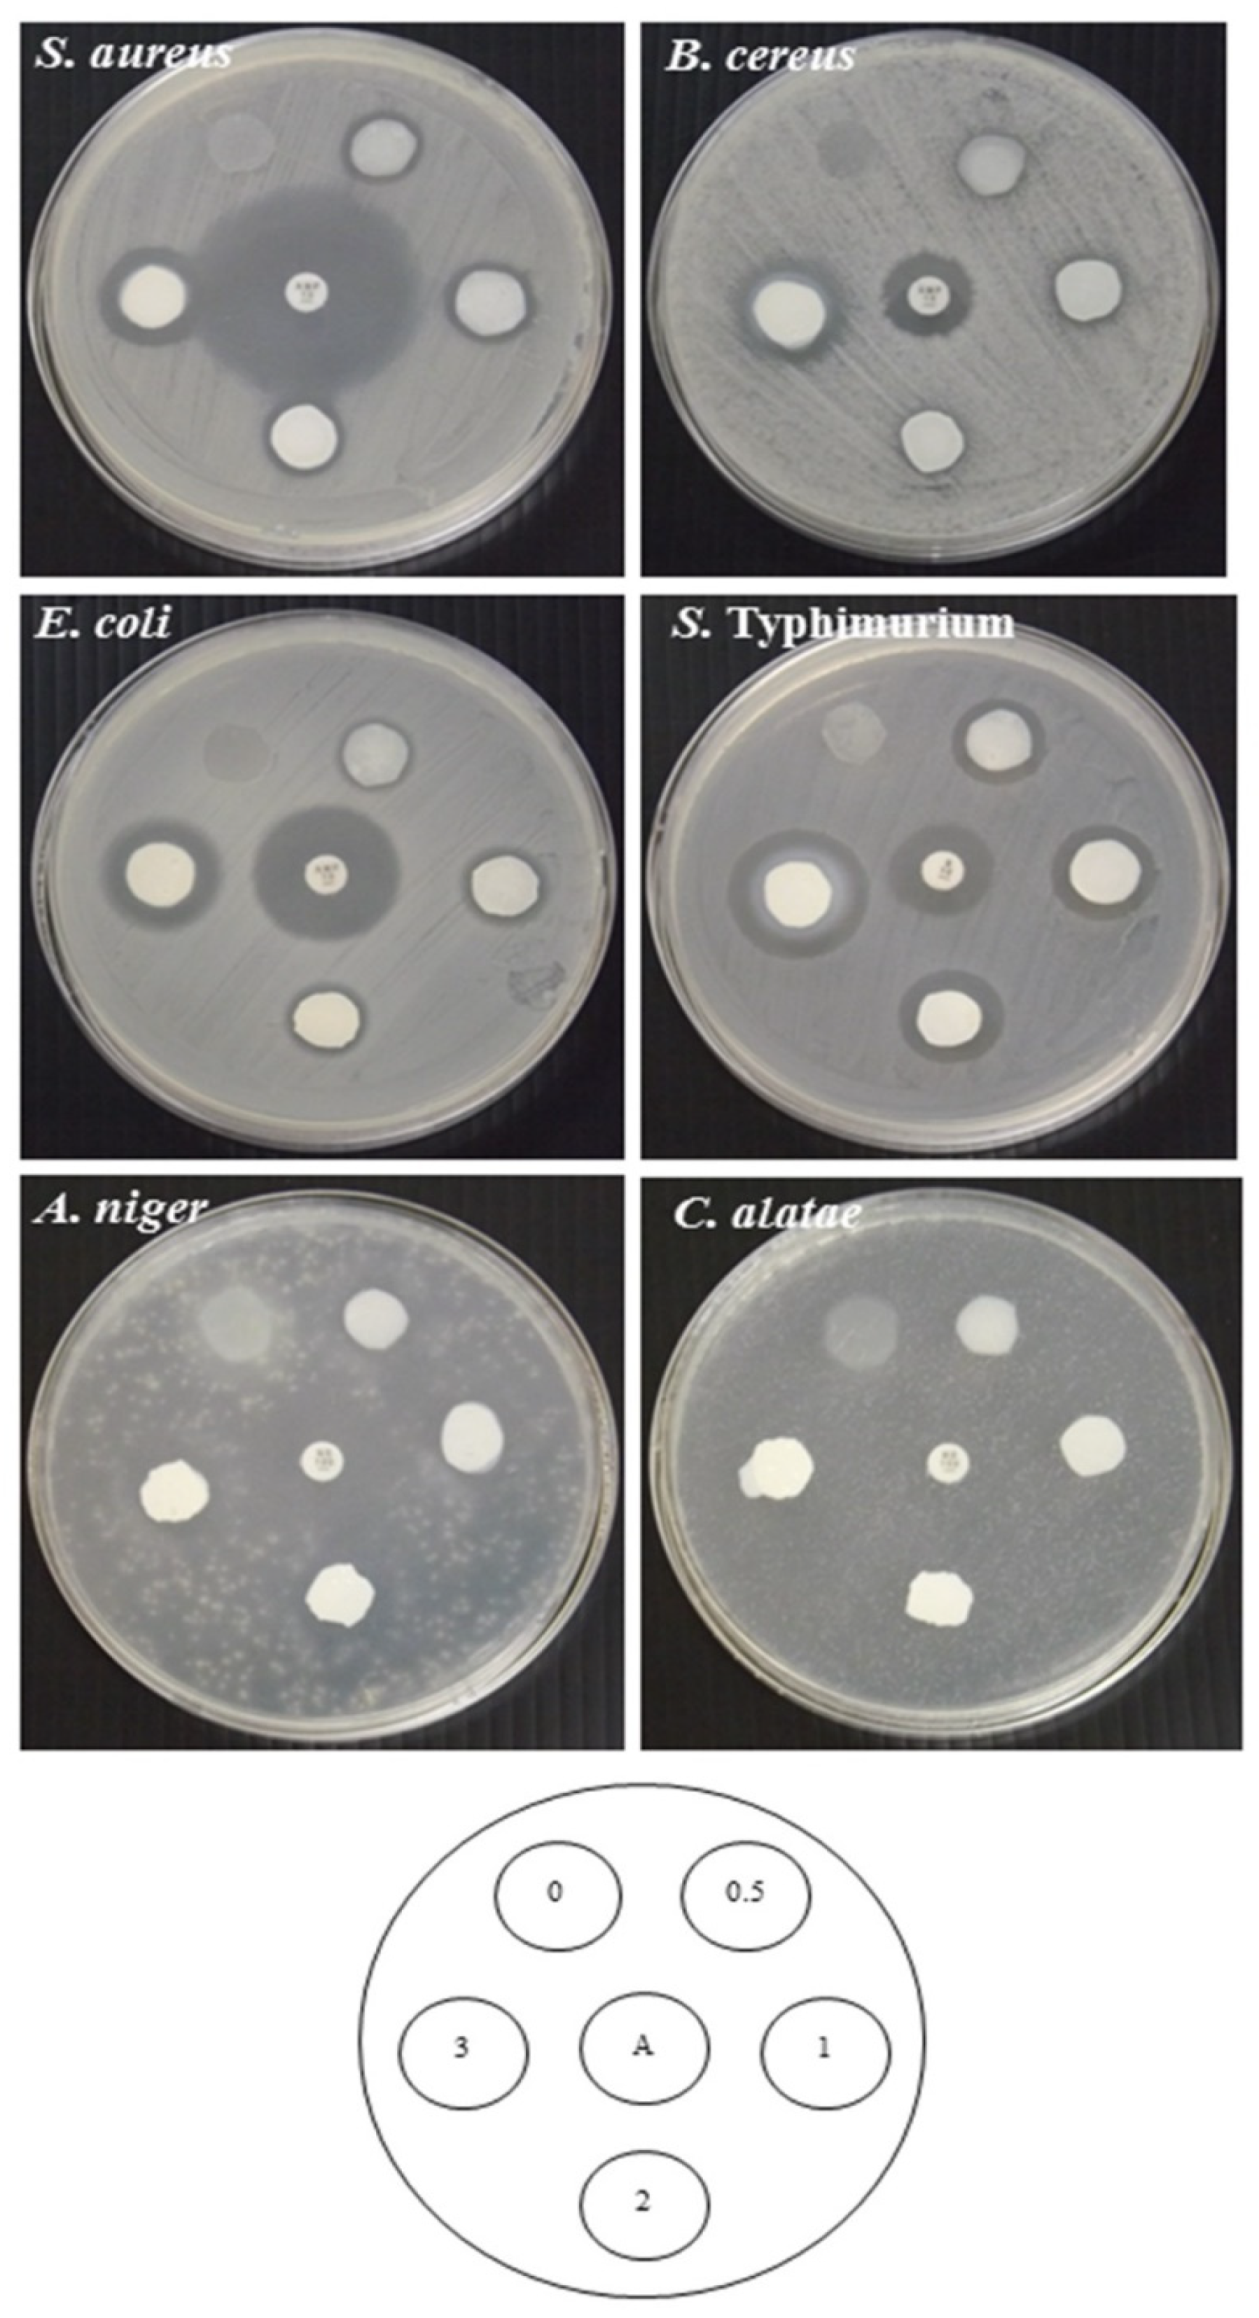

Enhancing the UV-Light Barrier, Thermal Stability, Tensile Strength, and Antimicrobial Properties of Rice Starch–Gelatin Composite Films through the Incorporation of Zinc Oxide Nanoparticles
Abstract
:1. Introduction
2. Materials and Methods
2.1. Materials and Microbials
2.2. Preparation of Asiatic Pennywort Extract and ZnONPs
2.3. Preparation of Rice Starch–Gelatin Films Incorporated with ZnONPs
2.4. Film Properties Determinations
2.4.1. Film Thickness
2.4.2. Mechanical Properties
2.4.3. Film Appearance, Color, Optical Properties, and Morphology
2.4.4. Moisture Content and Film Solubility
2.4.5. Water Vapor Permeability
2.4.6. FT-IR Spectroscopy Analysis
2.4.7. XRD Analysis
2.4.8. TGA Analysis
2.4.9. Antimicrobial Properties
2.5. Statistical Analysis
3. Results and Discussion
3.1. The Characterization of ZnONPs
3.2. Properties of RS–G–ZnONPs Nanocomposite Films
3.2.1. Film Thickness
3.2.2. Mechanical Properties
3.2.3. Film Appearance, Color, Optical Properties, and Morphology
3.2.4. Moisture Content and Film Solubility
3.2.5. Water Vapor Permeability (WVP)
3.2.6. FT-IR Spectroscopy
3.2.7. XRD Results
3.2.8. TGA Results
3.2.9. Antimicrobial Activity
4. Conclusions
Author Contributions
Funding
Institutional Review Board Statement
Informed Consent Statement
Data Availability Statement
Acknowledgments
Conflicts of Interest
References
- Dilkes-Hoffman, L.S.; Lane, J.L.; Grant, T.; Pratt, S.; Lant, P.A.; Laycock, B. Environmental impact of biodegradable food packaging when considering food waste. J. Clean. Prod. 2018, 180, 325–334. [Google Scholar] [CrossRef]
- Ren, Y.; Rong, L.; Shen, M.; Liu, W.; Xiao, W.; Luo, Y.; Xie, J. Interaction between rice starch and Mesona chinensis Benth polysaccharide gels: Pasting and gelling properties. Carbohydr. Polym. 2020, 240, 116316. [Google Scholar] [CrossRef] [PubMed]
- Dias, A.B.; Müller, C.M.O.; Larotonda, F.D.S.; Laurindo, J.B. Biodegradable films based on rice starch and rice flour. J. Cereal Sci. 2010, 51, 213–219. [Google Scholar] [CrossRef]
- Jaymand, M. Sulfur functionality-modified starches: Review of synthesis strategies, properties, and applications. Int. J. Biol. Macromol. 2022, 197, 111–120. [Google Scholar] [CrossRef]
- Thakur, R.; Pristijono, P.; Golding, J.B.; Stathopoulos, C.E.; Scarlett, C.; Bowyer, M.; Singh, S.P.; Vuong, Q.V. Effect of starch physiology, gelatinization, and retrogradation on the attributes of rice starch-ι-carrageenan film. Starch Stärke 2018, 70, 1700099. [Google Scholar] [CrossRef] [Green Version]
- Ahmad, M.; Hani, N.M.; Nirmal, N.P.; Fazial, F.F.; Mohtar, N.F.; Romli, S.R. Optical and thermo-mechanical properties of composite films based on fish gelatin/rice flour fabricated by casting technique. Prog. Org. Coat. 2015, 84, 115–127. [Google Scholar] [CrossRef]
- Fakhouri, F.M.; Martelli, S.M.; Caon, T.; Velasco, J.I.; Mei, L.H.I. Edible films and coatings based on starch/gelatin: Film properties and effect of coatings on quality of refrigerated Red Crimson grapes. Postharvest Biol. Technol. 2015, 109, 57–64. [Google Scholar] [CrossRef]
- Tiozon, R.J.N.; Bonto, A.P.; Sreenivasulu, N. Enhancing the functional properties of rice starch through biopolymer blending for industrial applications: A review. Int. J. Biol. Macromol. 2021, 192, 100–117. [Google Scholar] [CrossRef]
- Kumar, S.; Boro, J.C.; Ray, D.; Mukherjee, A.; Dutta, J. Bionanocomposite films of agar incorporated with ZnO nanoparticles as an active packaging material for shelf life extension of green grape. Heliyon 2019, 5. [Google Scholar] [CrossRef] [Green Version]
- Arroyo, B.J.; Bezerra, A.C.; Oliveira, L.L.; Arroyo, S.J.; Melo, E.A.d.; Santos, A.M.P. Antimicrobial active edible coating of alginate and chitosan add ZnO nanoparticles applied in guavas (Psidium guajava L.). Food Chem. 2020, 309, 125566. [Google Scholar] [CrossRef]
- Oun, A.A.; Rhim, J.-W. Carrageenan-based hydrogels and films: Effect of ZnO and CuO nanoparticles on the physical, mechanical, and antimicrobial properties. Food Hydrocoll. 2017, 67, 45–53. [Google Scholar] [CrossRef]
- Shahvalizadeh, R.; Ahmadi, R.; Davandeh, I.; Pezeshki, A.; Seyed Moslemi, S.A.; Karimi, S.; Rahimi, M.; Hamishehkar, H.; Mohammadi, M. Antimicrobial bio-nanocomposite films based on gelatin, tragacanth, and zinc oxide nanoparticles—Microstructural, mechanical, thermo-physical, and barrier properties. Food Chem. 2021, 354, 129492. [Google Scholar] [CrossRef] [PubMed]
- Agarwal, H.; Kumar, S.V.; Rajeshkumar, S. A review on green synthesis of zinc oxide nanoparticles—An eco-friendly approach. Resour.-Effic. Technol. 2017, 3, 406–413. [Google Scholar] [CrossRef]
- Soto-Robles, C.A.; Nava, O.; Cornejo, L.; Lugo-Medina, E.; Vilchis-Nestor, A.R.; Castro-Beltrán, A.; Luque, P.A. Biosynthesis, characterization and photocatalytic activity of ZnO nanoparticles using extracts of Justicia spicigera for the degradation of methylene blue. J. Mol. Struct. 2021, 1225, 129101. [Google Scholar] [CrossRef]
- Nava, O.J.; Luque, P.A.; Gómez-Gutiérrez, C.M.; Vilchis-Nestor, A.R.; Castro-Beltrán, A.; Mota-González, M.L.; Olivas, A. Influence of Camellia sinensis extract on Zinc Oxide nanoparticle green synthesis. J. Mol. Struct. 2017, 1134, 121–125. [Google Scholar] [CrossRef]
- Yassin, M.A.; Elgorban, A.M.; El-Samawaty, A.E.-R.M.A.; Almunqedhi, B.M.A. Biosynthesis of silver nanoparticles using Penicillium verrucosum and analysis of their antifungal activity. Saudi J. Biol. Sci. 2021, 28, 2123–2127. [Google Scholar] [CrossRef] [PubMed]
- Shankar, S.; Wang, L.-F.; Rhim, J.-W. Incorporation of zinc oxide nanoparticles improved the mechanical, water vapor barrier, UV-light barrier, and antibacterial properties of PLA-based nanocomposite films. Mater. Sci. Eng. C 2018, 93, 289–298. [Google Scholar] [CrossRef]
- Noshirvani, N.; Ghanbarzadeh, B.; Mokarram, R.R.; Hashemi, M.; Coma, V. Preparation and characterization of active emulsified films based on chitosan-carboxymethyl cellulose containing zinc oxide nano particles. Int. J. Biol. Macromol. 2017, 99, 530–538. [Google Scholar] [CrossRef]
- Nourbakhsh, S.; Talebian, A.; Faramarzi, S. Preparation and characterization of Gelatin/ZnO nano-composite film. Mater. Today Proc. 2017, 4, 7038–7043. [Google Scholar] [CrossRef]
- Ahmadi, A.; Ahmadi, P.; Sani, M.A.; Ehsani, A.; Ghanbarzadeh, B. Functional biocompatible nanocomposite films consisting of selenium and zinc oxide nanoparticles embedded in gelatin/cellulose nanofiber matrices. Int. J. Biol. Macromol. 2021, 175, 87–97. [Google Scholar] [CrossRef]
- Polash, S.; Saha, T.; Hossain, M.; Sarker, S. Phytochemical contents, antioxidant and antibacterial activity of the ethanolic extracts of Centella asiatica (L.) Urb.leaf and stem. Jahangirnagar Univ. J. Biol. Sci. 2017, 6, 51–57. [Google Scholar] [CrossRef] [Green Version]
- Selim, Y.A.; Azb, M.A.; Ragab, I.; Abd El-Azim, M.H.M. Green Synthesis of Zinc Oxide Nanoparticles Using Aqueous Extract of Deverra tortuosa and their Cytotoxic Activities. Sci. Rep. 2020, 10, 3445. [Google Scholar] [CrossRef] [PubMed] [Green Version]
- Basnet, P.; Chanu, I.T.; Samanta, D.; Chatterjee, S. A review on bio-synthesized zinc oxide nanoparticles using plant extracts as reductants and stabilizing agents. J. Photochem. Photobiol. B Biol. 2018, 183, 201–221. [Google Scholar] [CrossRef] [PubMed]
- Raj, L.F.A.; Jayalakshmy, E. Biosynthesis and Characterization of Zinc Oxide Nanoparticles Using Root Extract of Zingiber Officinale. Orient. J. Chem. 2015, 31, 51–56. [Google Scholar] [CrossRef]
- Naseer, M.; Aslam, U.; Khalid, B.; Chen, B. Green route to synthesize Zinc Oxide Nanoparticles using leaf extracts of Cassia fistula and Melia azadarach and their antibacterial potential. Sci. Rep. 2020, 10, 9055. [Google Scholar] [CrossRef]
- Marvizadeh, M.M.; Oladzadabbasabadi, N.; Nafchi, A.; Jokar, M. Preparation and characterization of bionanocomposite film based on tapioca starch/bovine gelatin/nanorod zinc oxide. Int. J. Biol. Macromol. 2017, 99, 1–7. [Google Scholar] [CrossRef]
- Kaewprachu, P.; Osako, K.; Rungraeng, N.; Rawdkuen, S. Characterization of fish myofibrillar protein film incorporated with catechin-Kradon extract. Int. J. Biol. Macromol. 2018, 107, 1463–1473. [Google Scholar] [CrossRef]
- Han, J.H.; Floros, J.D. Casting Antimicrobial Packaging Films and Measuring Their Physical Properties and Antimicrobial Activity. J. Plast. Film Sheeting 1997, 13, 287–298. [Google Scholar] [CrossRef]
- AOAC. Official Methods of Analysis: Method No. 927.05; AOAC International: Rockville, MD, USA, 1999. [Google Scholar]
- ASTM. Standard test methods for water vapor transmission of materials. Standard designation E96–E80. In Annual Book of ASTM Standards; ASTM International: West Conshohocken, PA, USA, 1989; pp. 761–770. [Google Scholar]
- Rawdkuen, S.; Sai-Ut, S.; Benjakul, S. Properties of gelatin films from giant catfish skin and bovine bone: A comparative study. Eur. Food Res. Technol. 2010, 231, 907–916. [Google Scholar] [CrossRef]
- Bhatte, K.D.; Sawant, D.N.; Pinjari, D.V.; Pandit, A.B.; Bhanage, B.M. One pot green synthesis of nano sized zinc oxide by sonochemical method. Mater. Lett. 2012, 77, 93–95. [Google Scholar] [CrossRef]
- Bhuyan, T.; Mishra, K.; Khanuja, M.; Prasad, R.; Varma, A. Biosynthesis of zinc oxide nanoparticles from Azadirachta indica for antibacterial and photocatalytic applications. Mater. Sci. Semicond. Process. 2015, 32, 55–61. [Google Scholar] [CrossRef]
- Orsuwan, A.; Shankar, S.; Wang, L.-F.; Sothornvit, R.; Rhim, J.-W. Preparation of antimicrobial agar/banana powder blend films reinforced with silver nanoparticles. Food Hydrocoll. 2016, 60, 476–485. [Google Scholar] [CrossRef]
- Wang, L.-F.; Rhim, J.-W. Preparation and application of agar/alginate/collagen ternary blend functional food packaging films. Int. J. Biol. Macromol. 2015, 80, 460–468. [Google Scholar] [CrossRef] [PubMed]
- Ejaz, M.; Arfat, Y.A.; Mulla, M.; Ahmed, J. Zinc oxide nanorods/clove essential oil incorporated Type B gelatin composite films and its applicability for shrimp packaging. Food Packag. Shelf Life 2018, 15, 113–121. [Google Scholar] [CrossRef]
- Shaili, T.; Abdorreza, M.N.; Fariborz, N. Functional, thermal, and antimicrobial properties of soluble soybean polysaccharide biocomposites reinforced by nano TiO2. Carbohydr. Polym. 2015, 134, 726–731. [Google Scholar] [CrossRef] [PubMed]
- Kim, S.; Song, K.B. Antimicrobial activity of buckwheat starch films containing zinc oxide nanoparticles against Listeria monocytogenes on mushrooms. Int. J. Food Sci. Technol. 2018, 53, 1549–1557. [Google Scholar] [CrossRef]
- Baek, S.-K.; Song, K.B. Development of Gracilaria vermiculophylla extract films containing zinc oxide nanoparticles and their application in smoked salmon packaging. LWT 2018, 89, 269–275. [Google Scholar] [CrossRef]
- Ahmed, J.; Arfat, Y.A.; Al-Attar, H.; Auras, R.; Ejaz, M. Rheological, structural, ultraviolet protection and oxygen barrier properties of linear low- density polyethylene films reinforced with zinc oxide (ZnO) nanoparticles. Food Packag. Shelf Life 2017, 13, 20–26. [Google Scholar] [CrossRef]
- Arfat, Y.A.; Benjakul, S.; Prodpran, T.; Sumpavapol, P.; Songtipya, P. Physico-Mechanical Characterization and Antimicrobial Properties of Fish Protein Isolate/Fish Skin Gelatin-Zinc Oxide (ZnO) Nanocomposite Films. Food Bioprocess Technol. 2016, 9, 101–112. [Google Scholar] [CrossRef]
- Farahnaky, A.; Dadfar, S.M.M.; Shahbazi, M. Physical and mechanical properties of gelatin–clay nanocomposite. J. Food Eng. 2014, 122, 78–83. [Google Scholar] [CrossRef]
- Suriyatem, R.; Auras, R.A.; Rachtanapun, P. Utilization of Carboxymethyl Cellulose from Durian Rind Agricultural Waste to Improve Physical Properties and Stability of Rice Starch-Based Film. J. Polym. Environ. 2019, 27, 286–298. [Google Scholar] [CrossRef]
- Rouhi, J.; Mahmud, S.; Naderi, N.; Ooi, C.H.R.; Mahmood, M.R. Physical properties of fish gelatin-based bio-nanocomposite films incorporated with ZnO nanorods. Nanoscale Res. Lett. 2013, 8, 364. [Google Scholar] [CrossRef] [PubMed] [Green Version]
- Guz, L.; Famá, L.; Candal, R.; Goyanes, S. Size effect of ZnO nanorods on physicochemical properties of plasticized starch composites. Carbohydr. Polym. 2017, 157, 1611–1619. [Google Scholar] [CrossRef]
- Zhang, X.; Liu, Y.; Yong, H.; Qin, Y.; Liu, J.; Liu, J. Development of multifunctional food packaging films based on chitosan, TiO2 nanoparticles and anthocyanin-rich black plum peel extract. Food Hydrocoll. 2019, 94, 80–92. [Google Scholar] [CrossRef]
- Qin, Y.; Liu, Y.; Yuan, L.; Yong, H.; Liu, J. Preparation and characterization of antioxidant, antimicrobial and pH-sensitive films based on chitosan, silver nanoparticles and purple corn extract. Food Hydrocoll. 2019, 96, 102–111. [Google Scholar] [CrossRef]
- Gutiérrez, T.J. Are modified pumpkin flour/plum flour nanocomposite films biodegradable and compostable? Food Hydrocoll. 2018, 83, 397–410. [Google Scholar] [CrossRef]
- Shankar, S.; Tanomrod, N.; Rawdkuen, S.; Rhim, J.-W. Preparation of pectin/silver nanoparticles composite films with UV-light barrier and properties. Int. J. Biol. Macromol. 2016, 92, 842–849. [Google Scholar] [CrossRef]
- Ortega, F.; Giannuzzi, L.; Arce, V.B.; García, M.A. Active composite starch films containing green synthetized silver nanoparticles. Food Hydrocoll. 2017, 70, 152–162. [Google Scholar] [CrossRef]
- Mohammadi, H.; Kamkar, A.; Misaghi, A. Nanocomposite films based on CMC, okra mucilage and ZnO nanoparticles: Physico mechanical and antibacterial properties. Carbohydr. Polym. 2018, 181, 351–357. [Google Scholar] [CrossRef]
- Cheviron, P.; Gouanvé, F.; Espuche, E. Starch/silver nanocomposite: Effect of thermal treatment temperature on the morphology, oxygen and water transport properties. Carbohydr. Polym. 2015, 134, 635–645. [Google Scholar] [CrossRef]
- Azizi-Lalabadi, M.; Rafiei, L.; Divband, B.; Ehsani, A. Active packaging for Salmon stored at refrigerator with Polypropylene nanocomposites containing 4A zeolite, ZnO nanoparticles, and green tea extract. Food Sci. Nutr. 2020, 8, 6445–6456. [Google Scholar] [CrossRef] [PubMed]
- Lizundia, E.; Urruchi, A.; Vilas, J.L.; León, L.M. Increased functional properties and thermal stability of flexible cellulose nanocrystal/ZnO films. Carbohydr. Polym. 2016, 136, 250–258. [Google Scholar] [CrossRef] [PubMed]
- Azizi-Lalabadi, M.; Alizadeh-Sani, M.; Divband, B.; Ehsani, A.; McClements, D.J. Nanocomposite films consisting of functional nanoparticles (TiO2 and ZnO) embedded in 4A-Zeolite and mixed polymer matrices (gelatin and polyvinyl alcohol). Food Res. Int. 2020, 137, 109716. [Google Scholar] [CrossRef] [PubMed]
- Bourtoom, T.; Chinnan, M.S. Preparation and properties of rice starch–chitosan blend biodegradable film. LWT Food Sci. Technol. 2008, 41, 1633–1641. [Google Scholar] [CrossRef]
- Doan Thi, T.U.; Nguyen, T.T.; Thi, Y.D.; Ta Thi, K.H.; Phan, B.T.; Pham, K.N. Green synthesis of ZnO nanoparticles using orange fruit peel extract for antibacterial activities. RSC Adv. 2020, 10, 23899–23907. [Google Scholar] [CrossRef]
- Kaewprachu, P.; Jaisan, C.; Klunklin, W.; Phongthai, S.; Rawdkuen, S.; Tongdeesoontorn, W. Mechanical and Physicochemical Properties of Composite Biopolymer Films Based on Carboxymethyl Cellulose from Young Palmyra Palm Fruit Husk and Rice Flour. Polymers 2022, 14, 1872. [Google Scholar] [CrossRef]
- Akman, F.; Kazachenko, A.S.; Vasilyeva, N.Y.; Malyar, Y.N. Synthesis and characterization of starch sulfates obtained by the sulfamic acid-urea complex. J. Mol. Struct. 2020, 1208, 127899. [Google Scholar] [CrossRef]
- Govindaraju, I.; Zhuo, G.-Y.; Chakraborty, I.; Melanthota, S.K.; Mal, S.S.; Sarmah, B.; Baruah, V.J.; Mahato, K.K.; Mazumder, N. Investigation of structural and physico-chemical properties of rice starch with varied amylose content: A combined microscopy, spectroscopy, and thermal study. Food Hydrocoll. 2022, 122, 107093. [Google Scholar] [CrossRef]
- Jebel, F.S.; Almasi, H. Morphological, physical, antimicrobial and release properties of ZnO nanoparticles-loaded bacterial cellulose films. Carbohydr. Polym. 2016, 149, 8–19. [Google Scholar] [CrossRef]
- Rhim, J.-W.; Hong, S.-I.; Park, H.-M.; Ng, P.K.W. Preparation and Characterization of Chitosan-Based Nanocomposite Films with Antimicrobial Activity. J. Agric. Food Chem. 2006, 54, 5814–5822. [Google Scholar] [CrossRef]
- Shankar, S.; Teng, X.; Li, G.; Rhim, J.-W. Preparation, characterization, and antimicrobial activity of gelatin/ZnO nanocomposite films. Food Hydrocoll. 2015, 45, 264–271. [Google Scholar] [CrossRef]
- Lipovsky, A.; Tzitrinovich, Z.; Friedmann, H.; Applerot, G.; Gedanken, A.; Lubart, R. EPR Study of Visible Light-Induced ROS Generation by Nanoparticles of ZnO. J. Phys. Chem. C 2009, 113, 15997–16001. [Google Scholar] [CrossRef]
- Lipovsky, A.; Nitzan, Y.; Gedanken, A.; Lubart, R. Antifungal activity of ZnO nanoparticles—the role of ROS mediated cell injury. Nanotechnology 2011, 22, 105101. [Google Scholar] [CrossRef] [PubMed]
- Sirelkhatim, A.; Mahmud, S.; Seeni, A.; Kaus, N.H.M.; Ann, L.C.; Bakhori, S.K.M.; Hasan, H.; Mohamad, D. Review on zinc oxide nanoparticles: Antibacterial activity and toxicity mechanism. Nano-Micro Lett. 2015, 7, 219–242. [Google Scholar] [CrossRef] [Green Version]
- Tayel, A.; El-Tras, W.; Moussa, S.; El Baz, A.; Mahrous, H.; Salem, D.M.; Brimer, L. Antibacterial Action of Zinc Oxide Nanoparticles against Foodborne Pathogens. J. Food Saf. 2011, 31, 211–218. [Google Scholar] [CrossRef]

| ZnONPs (% w/v) | Thickness (mm) | TS (MPa) | EAB (%) | Transparency | MC (%) | FS (%) | WVP (× 10−11 g m/m2 s Pa) |
|---|---|---|---|---|---|---|---|
| 0 | 0.050 ± 0.002 d | 3.49 ± 0.31 c | 92.20 ± 9.74 a | 3.21 ± 0.01 a | 18.86 ± 1.85 a | 67.84 ± 1.02 a | 5.52 ± 0.25 b |
| 0.5 | 0.055 ± 0.002 c | 3.55 ± 0.18 c | 57.43 ± 3.43 b | 2.25 ± 0.06 b | 17.15 ± 0.69 ab | 63.23 ± 0.28 b | 5.84 ± 0.28 b |
| 1 | 0.060 ± 0.001 b | 3.66 ± 0.20 bc | 52.10 ± 8.55 b | 1.64 ± 0.02 c | 17.02 ± 1.15 ab | 48.07 ± 0.95 c | 6.15 ± 0.32 b |
| 2 | 0.069 ± 0.002 a | 3.80 ± 0.17 b | 43.75 ± 8.55 c | 1.22 ± 0.09 d | 15.02 ± 0.45 bc | 40.61 ± 2.02 d | 7.26 ± 0.49 a |
| 3 | 0.070 ± 0.001 a | 4.63 ± 0.28 a | 37.68 ± 2.58 d | 0.91 ± 0.08 e | 13.08 ± 1.02 c | 30.36 ± 1.72 e | 7.45 ± 0.25 a |
Publisher’s Note: MDPI stays neutral with regard to jurisdictional claims in published maps and institutional affiliations. |
© 2022 by the authors. Licensee MDPI, Basel, Switzerland. This article is an open access article distributed under the terms and conditions of the Creative Commons Attribution (CC BY) license (https://creativecommons.org/licenses/by/4.0/).
Share and Cite
Homthawornchoo, W.; Kaewprachu, P.; Pinijsuwan, S.; Romruen, O.; Rawdkuen, S. Enhancing the UV-Light Barrier, Thermal Stability, Tensile Strength, and Antimicrobial Properties of Rice Starch–Gelatin Composite Films through the Incorporation of Zinc Oxide Nanoparticles. Polymers 2022, 14, 2505. https://doi.org/10.3390/polym14122505
Homthawornchoo W, Kaewprachu P, Pinijsuwan S, Romruen O, Rawdkuen S. Enhancing the UV-Light Barrier, Thermal Stability, Tensile Strength, and Antimicrobial Properties of Rice Starch–Gelatin Composite Films through the Incorporation of Zinc Oxide Nanoparticles. Polymers. 2022; 14(12):2505. https://doi.org/10.3390/polym14122505
Chicago/Turabian StyleHomthawornchoo, Wantida, Pimonpan Kaewprachu, Suttiporn Pinijsuwan, Orapan Romruen, and Saroat Rawdkuen. 2022. "Enhancing the UV-Light Barrier, Thermal Stability, Tensile Strength, and Antimicrobial Properties of Rice Starch–Gelatin Composite Films through the Incorporation of Zinc Oxide Nanoparticles" Polymers 14, no. 12: 2505. https://doi.org/10.3390/polym14122505
APA StyleHomthawornchoo, W., Kaewprachu, P., Pinijsuwan, S., Romruen, O., & Rawdkuen, S. (2022). Enhancing the UV-Light Barrier, Thermal Stability, Tensile Strength, and Antimicrobial Properties of Rice Starch–Gelatin Composite Films through the Incorporation of Zinc Oxide Nanoparticles. Polymers, 14(12), 2505. https://doi.org/10.3390/polym14122505

